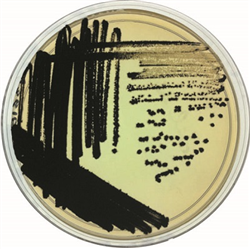

聯係我們
麻豆文化传媒精品观看企業集團有限公(gōng)司
麻豆文化传媒精品观看行儀器有限公司
電(diàn)話:020-34821111 (50條線)
傳(chuán)真:020-34820098 (銷售部)
020-34829878 (維修(xiū)部)
郵(yóu)編:511442
地址:廣州市番(fān)禺區興南大道483號麻豆文化传媒精品观看大(dà)廈


BIOLOG公司利用其(qí)表型芯片技術平台,優化篩選出(chū)一(yī)係列優質的致病菌顯色培養基,包括沙門氏菌、誌(zhì)賀氏(shì)菌和大腸杆菌O157三種(zhǒng)顯色培養基,用於食品和製藥行業致病菌檢測,減少雜菌幹擾,提高檢出率。 Rainbow Agar係列顯色培養基為幹粉產品,采用小包裝,避免大包(bāo)裝的吸潮風險(xiǎn)。
Copyright © 2021 HUAYUE Inc. All Rights Reserved
粵ICP備11098197號
廣州(zhōu)市麻豆文化传媒精品观看行儀器有限公司 版權(quán)所有
廣州(zhōu)市麻豆文化传媒精品观看行儀器有限公司 版權(quán)所有